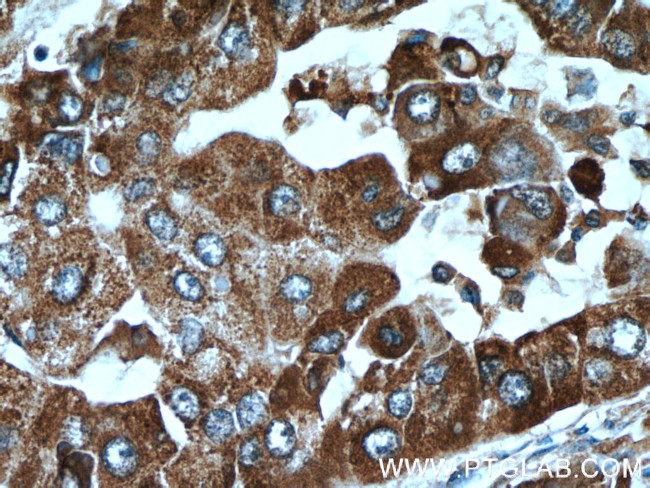
C10orf125 Antibody in Immunohistochemistry (Paraffin) (IHC (P))

Search
Proteintech
C10orf125 Polyclonal Antibody
{{$productOrderCtrl.translations['antibody.pdp.commerceCard.promotion.promotions']}}
{{$productOrderCtrl.translations['antibody.pdp.commerceCard.promotion.viewpromo']}}
{{$productOrderCtrl.translations['antibody.pdp.commerceCard.promotion.promocode']}}: {{promo.promoCode}} {{promo.promoTitle}} {{promo.promoDescription}}. {{$productOrderCtrl.translations['antibody.pdp.commerceCard.promotion.learnmore']}}
产品信息
24537-1-AP
种属反应
宿主/亚型
分类
类型
抗原
偶联物
形式
浓度
纯化类型
保存液
内含物
保存条件
运输条件
产品详细信息
Immunogen sequence: MVALKGVPA LLSPELLYAL ARMGHGDEIV LADLNFPASS ICQCGPMEIR ADGLGIPQLL EAVLKLLPLD TYVESPAAVM ELVPSDKERG LQTPVWTEYE SILRRAGCVR ALAKIERFEF YERAKKAFAV VATGC (1-134 aa encoded by BC129819)
靶标信息
Involved in the interconversion between alpha- and beta-L-fucoses. L-Fucose (6-deoxy-L-galactose) exists as alpha-L-fucose (29.5%) and beta-L-fucose (70.5%), the beta-form is metabolized through the salvage pathway. GDP-L-fucose formed either by the de novo or salvage pathways is transported into the endoplasmic reticulum, where it serves as a substrate for N- and O-glycosylations by fucosyltransferases. Fucosylated structures expressed on cell surfaces or secreted in biological fluids are believed to play a critical role in cell-cell adhesion and recognition processes.
仅用于科研。不用于诊断过程。未经明确授权不得转售。
篇参考文献 (0)
生物信息学
蛋白别名: Fucose mutarotase; protein fucU homolog
基因别名: C10orf125; FucM; FUCU; FUOM
UniProt ID: (Human) A2VDF0
Entrez Gene ID: (Human) 282969